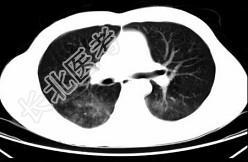

试题详情
- 单项选择题男,35岁, 被车撞伤后1小时,结合影像图像选择其最可能的诊断为 ( )

A、肺炎
B、肺结核
C、间质性肺炎
D、肺挫伤
E、支气管扩张
关注下方微信公众号,搜题查看答案

热门试题
- 下列哪项为胸腔损伤时行闭式胸膜腔引流术的
- 关于自发性食管破裂,叙述错误的是A、病因
- 血友病患者突发胸闷,气急, 体查见颈静脉
- 女性,50岁, 因进行性吞咽困难2个月,
- 关于后纵隔肿瘤,下列哪项不正确 (
- 食管癌病人出现进食呛咳,可能的原因有A、
- 螺旋CT自身的缺点不包括A、影像噪声增加
- 胸外伤反常呼吸的最根本的病理生理紊乱是A
- 胸腔积液中葡萄糖含量仅为1 mmol/L
- 最需要与贲门失弛缓症进行鉴别诊断的是A、
- 1、其诊断主要应考虑2、在该患者病程中曾
- 导致休克的原因很多,但都有一个共同点A、
- 肺动静脉瘘的手术方案包括A、肺楔形切除B
- 男性,65岁,3年前因右上肺腺癌行肺叶切
- 下列心电图表现中,低钾血症时最早的改变是
- 下列哪项食管吞钡的X线表现,显示食管癌已
- 二尖瓣狭窄,产生肺水肿的最可能的原因是A
- 最常见的胸壁畸形是以下哪种畸形A、漏斗胸
- 预防应用抗生素的指征,下面错误的是A、肠
- 男性,48岁, 背部肿块3cm×4cm,